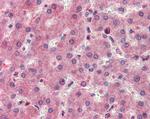
RASSF1 Antibody in Immunohistochemistry (Paraffin) (IHC (P))

Search
Invitrogen
RASSF1 Polyclonal Antibody
{{$productOrderCtrl.translations['antibody.pdp.commerceCard.promotion.promotions']}}
{{$productOrderCtrl.translations['antibody.pdp.commerceCard.promotion.viewpromo']}}
{{$productOrderCtrl.translations['antibody.pdp.commerceCard.promotion.promocode']}}: {{promo.promoCode}} {{promo.promoTitle}} {{promo.promoDescription}}. {{$productOrderCtrl.translations['antibody.pdp.commerceCard.promotion.learnmore']}}
图: 1 / 2
RASSF1 Antibody (PA5-142452) in IHC (P)

产品信息
PA5-142452
种属反应
宿主/亚型
分类
类型
抗原
偶联物
形式
浓度
规格
纯化类型
保存液
内含物
保存条件
运输条件
RRID
产品详细信息
Additional Information: This antibody is expected to recognize reported isoforms A, C and D (NP_009113.3; NP_733831.1; NP_733832.1) .
This antibody is tested in Peptide ELISA: antibody detection limit dilution 1:128,000.
靶标信息
This gene encodes a protein similar to the RAS effector proteins. Loss or altered expression of this gene has been associated with the pathogenesis of a variety of cancers, which suggests the tumor suppressor function of this gene. The inactivation of this gene was found to be correlated with the hypermethylation of its CpG-island promoter region. The encoded protein was found to interact with DNA repair protein XPA. The protein was also shown to inhibit the accumulation of cyclin D1, and thus induce cell cycle arrest. Seven alternatively spliced transcript variants of this gene encoding distinct isoforms have been reported.
仅用于科研。不用于诊断过程。未经明确授权不得转售。
篇参考文献 (0)
生物信息学
蛋白别名: cardiac-specific ras association domain family 1 protein; pancreas-specific ras association domain family 1 protein; putative RAS effector and tumor suppressor protein; Ras association (RalGDS/AF-6) domain family member 1; Ras association domain-containing protein 1; RASSF1A; RASSF1B; RASSF1C; RASSF1F; Ras association (RalGDS/AF-6) domain family 1; RASSF1G; Ras association (RalGDS/AF-6) domain family 1 protein; tumor suppressor protein RDA32; unnamed protein product; WUGSC:H_LUCA12.5
基因别名: 123F2; NORE2A; RASSF1; RASSF1A; RDA32; REH3P21
UniProt ID: (Human) Q9NS23
Entrez Gene ID: (Human) 11186




